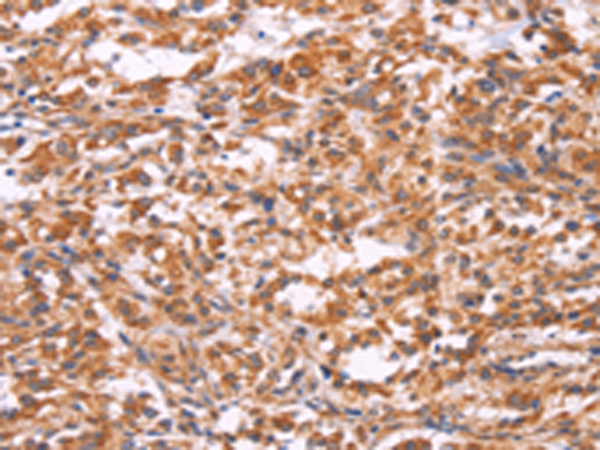
一抗

|
Background: |
EMP-2 (epithelial membrane protein 2), also known as XMP, is a 167 amino acid multi-pass membrane protein that contains four-transmembrane domains and belongs to the GAS3/PMP22 (growth arrest-specific-3/peripheral myelin protein-22) family. Localized to lipid raft domains in the plasma membrane, EMP-2 regulates the expression of several target proteins and is necessary for blastocyst implantation in the uterine endometrium. Specifically, EMP-2 mediates blastocyst implantation by controlling the cell membrane expression of MHC and glycosylphosphatidylinositol-anchored proteins, as well as Integrins and caveolin-1. In adult tissues, EMP-2 is expressed in heart, lung, ovary and intestine, while fetal expression is highest in kidney, brain and liver. Overexpression of EMP-2 is associated with endometrial adenocarcinoma, suggesting a possible role for EMP-2 in tumorigenesis. |
|
Applications: |
ELISA, IHC |
|
Name of antibody: |
EMP2 |
|
Immunogen: |
Synthetic peptide of human EMP2 |
|
Full name: |
epithelial membrane protein 2 |
|
Synonyms: |
XMP |
|
SwissProt: |
P54851 |
|
ELISA Recommended dilution: |
2000-5000 |
|
IHC positive control: |
Human thyroid cancer and Human ovarian cancer |
|
IHC Recommend dilution: |
50-200 |

 購物車
購物車 幫助
幫助
 021-54845833/15800441009
021-54845833/15800441009